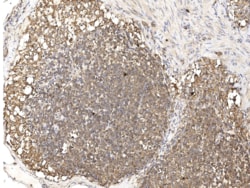
SNX2 Antibody, Novus Biologicals 25 &mu;g; Unconjugated:Antibodies

missing translation for 'onlineSavingsMsg'
Learn More
Learn More
SNX2 Antibody, Novus Biologicals™
Rabbit Polyclonal Antibody
Marca: Novus Biologicals NBP3-21431-25ul
Questo articolo non è restituibile.
Consulta la politica di reso
Descrizione
SNX2 Polyclonal antibody specifically detects SNX2 in Human samples. It is validated for Immunohistochemistry, Immunofluorescence, Immunohistochemistry (Paraffin)
Specifica
| SNX2 | |
| Polyclonal | |
| Immunohistochemistry, Immunocytochemistry/Immunofluorescence 1:50-1:200, Immunohistochemistry-Paraffin 1:50-1:200 | |
| MGC5204, sorting nexin 2, sorting nexin-2, Transformation-related gene 9 protein, TRG-9 | |
| Produced in rabbits immunized with E. coli-derived Human SNX2 fragment | |
| 25 μg | |
| Signal Transduction | |
| 6643 | |
| Store at 4C short term. Aliquot and store at -20C long term. Avoid freeze-thaw cycles. | |
| IgG |
| Immunohistochemistry, Immunofluorescence, Immunohistochemistry (Paraffin) | |
| Unconjugated | |
| PBS, pH 7.0 | |
| Rabbit | |
| Antigen and protein A Affinity-purified | |
| RUO | |
| Primary | |
| Human | |
| Purified |
Correzione del contenuto del prodotto
Fornite il vostro feedback sul contenuto del prodotto compilando il modulo sottostante.
Titolo del prodotto
Individuate un'opportunità di miglioramento?Condividi una correzione di contenuto